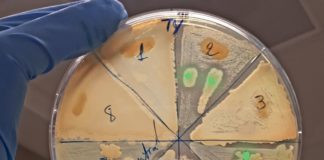
Cervelli al Sud, da Siviglia a Napoli per lo studio di microorganismi marini

Cervelli al Sud, da Siviglia a Napoli per lo studio di...
Brains to South è il bando promosso dalla Fondazione CON IL SUD, grazie al quale ricercatori stranieri o italiani, che svolgevano la loro attività...
Cervelli al Sud, da Zurigo a Cagliari per la ricerca su...
ROMA (ITALPRESS) - Walter Tarantino, 37 anni ha trasferito dal Politecnico Federale di Zurigo - ETH al Dipartimento di Fisica dell'Università di Cagliari le...
Cervelli al Sud, da Monaco a Palermo per lo studio dell’artrosi
ROMA (ITALPRESS) - Simone Dario Scilabra, 37 anni, è nato e cresciuto in Sicilia. Ha studiato, vissuto e lavorato all'estero molti anni. Al...
Coronavirus, da Philip Morris indennità 100%, Robotti “Priorità persone”
ROMA (ITALPRESS) - Integrazione al 100% dell'indennità economica riconosciuta dall'INPS nei casi di congedo per i lavoratori con figli sotto i 14 anni di...
Lamorgese “I decreti sicurezza hanno creato insicurezza”
ROMA (ITALPRESS) - "Responsabilità non ce n'è da parte nostra. I decreti sicurezza hanno creato insicurezza perchè 20mila persone sono dovute uscire dall'accoglienza da...
Uefa, il vicepresidente Michele Uva rassegna le dimissioni
ROMA (ITALPRESS) - Michele Uva lascia la Uefa. A comunicarlo è lo stesso vicepresidente della Confederazione del calcio europeo: "Nella giornata di ieri ho...
Peugeot Competition 208. Il siciliano Casella fa il bis al Due...
ROMA (ITALPRESS) - Il ventiseienne siciliano Alessandro Casella, dopo la vittoria al Rally del Ciocco, si è ripetuto a Verona nel secondo appuntamento per...
Tg News – 30/10/2020
In questa edizione:
- Lavoro, 9,7 milioni di dipendenti in attesa di rinnovo contrattuale
- Bce lascia tassi di interesse e dotazione PEPP invariati
- Credito, cresce...